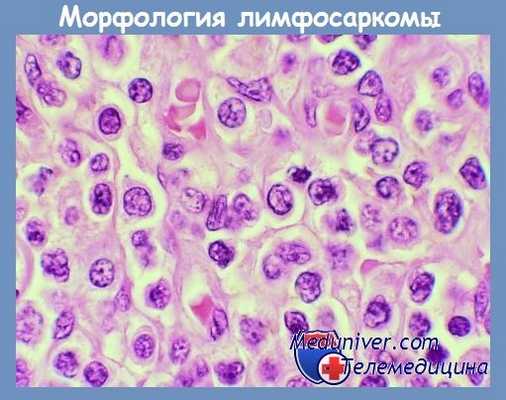
Лимфосаркома

Лабораторная диагностика лимфосаркомы - анализы
Добавил пользователь Владимир З. Обновлено: 31.12.2025
Информацию из данного раздела нельзя использовать для самодиагностики и самолечения. В случае боли или иного обострения заболевания диагностические исследования должен назначать только лечащий врач. Для постановки диагноза и правильного назначения лечения следует обращаться к Вашему лечащему врачу.
Саркома: причины появления, симптомы, диагностика и способы лечения.
Определение
Саркома — это злокачественная (раковая) опухоль, которая развивается в разных типах соединительной ткани. Различают несколько видов опухолей: остеогенную саркому (костная ткань), хондросаркому (хрящевая ткань), миосаркому (мышцы), липосаркому (жировая ткань), синовиальную (процесс затрагивает суставы, чаще страдают колени), фибросаркому (часто поражаются молочные железы), а также ангиосаркому (опухоли сосудистых стенок). Зачастую эти опухолевые процессы характеризуются быстрым ростом, частыми рецидивами и отдаленным метастазированием.
Причины возникновения саркомы
Точные причины развития саркомы мягких тканей точно не известны, но на развитие опухолевого процесса могут влиять следующие факторы:
Стадирование саркомы мягких тканей основано на размере образования, его расположении в отношении поверхностной фасции и степени злокачественности.
Саркомы низкой степени злокачественности сопряжены с низким (менее 5%) риском метастазирования (распространения на другие участки организма). Для саркомы высокой степени злокачественности характерен высокий риск метастазирования, чаще всего в легкие. Поражение близлежащих (регионарных) лимфоузлов встречается редко (5-10%).
Классификация заболевания
По происхождению:
- опухоль, растущая из костной ткани: остеосаркома, хондросаркома, саркома Юинга;
- опухоль, растущая из мягких тканей: липосаркома, лимфосаркома, фибросаркома, саркома Капоши.
- липосаркома, которая выглядит как жировая ткань;
- лейомиосаркома, которая выглядит как гладкие мышцы:
- матки,
- стенки пищеварительного тракта,
- стенки кровеносных сосудов;
При правильном и своевременном лечении при саркомах 5-летняя выживаемость составляет в среднем до 75%.
Симптомы саркомы
Начальными симптомами онкопроцесса становятся увеличение лимфатических узлов, выраженная слабость и быстрая утомляемость даже после отдыха.
Признаки и симптомы саркомы зависят от местонахождения опухоли. Некоторые симптомы саркомы:- боль в месте формирования опухоли;
- тошнота, рвота;
- выраженная слабость, быстрая утомляемость, упадок сил;
- потеря аппетита и снижение веса;
- опухоль (бугорок, «шишка») визуально определяется над поверхностью кожи;
- деформация костей, позвоночника;
- увеличение групп лимфатических узлов;
- полиорганная недостаточность – ухудшение функционирования всех органов и систем наблюдается при метастазировании опухоли;
- патологические переломы – характерный признак саркомы Юинга;
- цианозные (синюшные) пятна, бляшки или узлы – типичные проявления саркомы Капоши.
Если саркома растет в соединительной ткани внутренних органов, забрюшинного пространства, то манифестируют другие симптомы. Их характер зависит от места развития опухоли и ее размера, а также от проникновения в здоровые окружающие ткани. Так, например, при лейомиосаркоме матки могут быть кровотечения или длительные и болезненные менструации, а если саркома развивается в кишечнике, первым признаком может стать кишечная непроходимость (сначала частичная, потом полная).
Диагностика саркомы
Основополагающим диагностическим исследованием саркомы, на основании которого определяется тактика лечения и прогноз, является гистологическое исследование биопсийного материала и иммуногистохимическое исследование, дополненные молекулярными методами. Биопсия должна быть выполнена до начала комплексного лечения. В настоящее время широко используются два типа биопсий: игольная (тонкоигольная аспирация) и открытая биопсия.
Взятие биоматериала оплачивается отдельно. Согласно требованиям п. 17 Правил проведения патолого-анатомических исследований, утв. Приказом Минздрава Росс.
Согласно требованиям п. 17 Правил проведения патолого-анатомических исследований, утв. Приказом Минздрава России от 24.03.2016 № 179н, в целях уточнения диагноза.
Неспецифическая лабораторная диагностика включает:
Метод определения Определение физико-химических параметров выполняется на автоматическом анализаторе методом «сухой химии». Аппаратная микроскоп.
Синонимы: Общий анализ крови, ОАК. Full blood count, FBC, Complete blood count (CBC) with differential white blood cell count (CBC with diff), Hemogram. Краткое описание исследования Клинический анализ крови: общий.
Синонимы: Общий белок сыворотки крови; Общий сывороточный белок. Total Protein; Serum Тotal Protein; Total Serum Protein; TProt; ТР. Краткая характеристика определяемого вещества Общий бе�.
Синонимы: Общий билирубин крови; Общий билирубин сыворотки. Totalbilirubin; TBIL. Краткая характеристика определяемого вещества Билирубин общий Билирубин – пигмент �.
Синонимы: Диамид угольной кислоты; Карбамид; Мочевина в крови; Азот мочевины. Urea nitrogen; Urea; Blood Urea Nitrogen (BUN); Urea; Plasma Urea. Краткая характеристика аналита Мочевина Моче�.
Синонимы: Анализ крови на креатинин; Сывороточный креатинин; Креатинин сыворотки, оценка СКФ. Сreat; Сre; Blood Creatinine; Serum Creatinine; Serum Creat. Краткая характеристика определя�.
Синонимы: Глутамино-щавелевоуксусная трансаминаза; Глутамат-оксалоацетат-трансаминаза сыворотки крови (СГОТ); L-аспартат 2-оксоглутарат аминотрансфераза; ГЩТ. As.
Аланинаминотрансфераза − внутриклеточный фермент, участвующий в метаболизме аминокислот. Тест используют в диагностике поражений печени, сердечной и скелетн�.
Синонимы: Анализ крови на ЛДГ; Лактатдегидрогеназа; L-лактат; НАД+Оксидоредуктаза; Дегидрогеназа молочной кислоты. Lactate dehydrogenase, Total; Lactic dehydrogenase; LDH; LD. Кра.
Синонимы: Анализ крови на щелочную фосфатазу; Фосфатаза щёлочная. ALK PHOS; ALKP; ALPase; Alk Phos. Краткое описание определяемого вещества Щелочная фосфатаза Щелочная фо�.
Синонимы: Анализ крови на электролиты; Электролиты в сыворотке крови. Electrolyte Panel; Serum electrolyte test; Sodium, Potassium, Chloride; Na/K/Cl. Краткая характеристика определяемых �.
Общий кальций – основной компонент костной ткани и важнейший биогенный элемент, обладающий важными структурными, метаболическими и регуляторными функциями в .
Синонимы: Гемостазиограмма. Coagulation studies (coagulation profile, coag panel, coagulogram). Краткая характеристика исследования «Гемостазиограмма (коагулограмма) расширенная» .
Другие инструментальные методы:
- рентгенография костей скелета, суставов ;
- ультразвуковое исследование пораженной области:
- предстательной железы ,
- сосудов ,
- мочевыделительной системы ,
- щитовидной железы ,
- молочных желез,
Лечение саркомы
Долгое время единственным способом лечения больных с саркомами являлся хирургический метод, который остается наиболее часто применяемым и сегодня. Методами выбора являются радикальные операции (удаление опухоли с захватом здоровой ткани), резекция (удаление только опухоли) с последующей лучевой терапией или комплексное лечение с химиотерапией и лучевой терапией перед резекцией опухоли. Также существуют методики, подразумевающие проведение операций гамма- или киберножами.
Лучевая или химиотерапия перед операцией используются для сокращения размеров опухоли и увеличения возможности радикальной органосохраняющей резекции. После операции возможно продолжение лучевой терапии.
Широкие органосохраняющие резекции с пред- и/или послеоперационной химиотерапией показывают удовлетворительные отдаленные результаты при саркомах конечностей с высокой степенью злокачественности. При таких же саркомах туловища, области головы и шеи хирургический метод вместе с лучевой или химиотерапией также дают хороший локальный контроль заболевания.
Лечение забрюшинных сарком более сложное, т.к. радикальное удаление опухолей бывает затруднено, а возможность лучевой терапии с адекватной дозой облучения ограничена.
У больных с IV стадией процесса хирургический метод может быть также использован в случае операбельных легочных метастазов. Если удаление первичной опухоли при этом возможно, то в ряде случаев оперативное удаление метастазов обеспечивает длительную безрецидивную выживаемость и даже излечение. Чаще всего это наблюдается при изолированных легочных метастазах, когда их удаление возможно при отсутствии плеврального выпота и метастазов в лимфатические узлы средостения, а также при отсутствии противопоказаний для операции на грудной клетке.
Химиотерапия саркомы мягких тканей в последние годы претерпевает значительные изменения: меняются подходы к выбору лекарственных комбинаций в зависимости от вида саркомы, появляются новые лекарства, приобретает клинические перспективы таргетная терапия.
Выбор препаратов для химиотерапии индивидуален и основан на виде саркомы, ее расположении и степени злокачественности, а также от состояния больного.
Химиотерапия необходима при поражении костей (остеосаркоме).
![Остеосаркома.jpg]()
Таргетные препараты направлены на поражение или связывание определенных молекулярных мишеней в опухолевых клетках, не затрагивая при этом здоровые ткани. Эффективность и безопасность применения этой группы лекарств при разных онкологических заболеваниях постоянно изучаются. В результате расширяются возможности их назначения как самостоятельно, так и в комбинации с препаратами стандартной химиотерапии.
Правильно подобранная терапия даже в запущенных случаях может продлить жизнь, улучшить общее состояние и качество жизни пациента.
Рекомендуются следующие реабилитационные мероприятия:
- экзопротезирование для пациентов, перенесших калечащие операции;
- курсы ранней и отсроченной реабилитации для пациентов после органосохраняющего лечения.
Саркомы мягких тканей могут достигать больших размеров, давить на здоровые ткани и вызывать боль.
При распространении саркомы на другие органы нарушаются функции пораженного органа (например, при распространении саркомы в легкие развивается одышка).
Неблагоприятные факторы, влияющие на исход лечения:
- присоединение инфекции;
- наличие патологического перелома;
- развитие анемии, тромбоцитопенического синдрома, которые требуют трансфузии компонентов крови;
- удлинение интервалов между введением химиопрепаратов;
- редукция доз химиопрепаратов;
- несоблюдение пациентом рекомендаций в ходе лечения и при динамическом наблюдении.
Профилактика саркомы
Поскольку до сих пор не выяснены точные причины развития саркомы, профилактических мероприятий не существует. Профилактика по большей части касается пациентов, прошедших лечение саркомы. Она заключается в наблюдении у специалиста после окончания этапа комбинированного лечения: динамическое наблюдение проводится каждые 3 месяца в течение первых 2 лет, далее – раз в 6 месяцев до 5 лет. Обязательными процедурами являются: КТ грудной клетки, УЗИ области послеоперационного рубца.
- Клинические рекомендации «Саркомы мягких тканей» (взрослые). Разраб.: Ассоциация онкологов России, Восточно-Европейская группа по изучению сарком, Российское общество клинической онкологии. – 2020.
- Бенберин В.В., Байзаков Б.Т., Шаназаров Н.А., Зинченко С.В. Саркомы мягких тканей – современный взгляд на проблему // Вестник Авиценны. – 2019;21(2):291-7.
- Громова Е.Г., Бирюкова Л.С., Джумабаева Б.Т., Курмуков И.А. Практические рекомендации по коррекции нефротоксичности противоопухолевых препаратов // Злокачественные опухоли: Практические рекомендации RUSSCO №3s2, 2017 (Т. 7). – С. 540–552.
- Клинические рекомендации «Саркомы мягких тканей» (дети). Разраб.: Национальное общество детских гематологов. – 2020.
Лимфосаркома
Лимфосаркомы (неходжкинские лимфомы) — группа системных злокачественных опухолей иммунной системы. Данные новообразования происходят из клеток лимфоидной ткани, расположенной вне костного мозга. Разные виды опухоли отличаются по локализации, биологическим свойствам, строению, клиническим проявлениям, ответу на лечение и прогнозу.
Причины и группы риска
Точные причины развития лимфосарком не установлены, но выявлены основные факторы риска, которые повышают вероятность возникновения данного заболевания. К ним относятся:
- Некоторые инфекции (гепатит С, ВИЧ, Helicobacter pylori) могут провоцировать развитие лимфосаркомы желудка.
- Аутоиммунные заболевания: красная волчанка, ревматоидный артрит.
- Приобретенные и врожденные иммунодефицитные состояния. Многократно повышается риск развития лимфосаркомы у пациентов, которые принимают иммуносупрессивные препараты.
В группе риска находятся люди, которые имели контакт с различными веществами, например, бензол, некоторые гербициды и инсектициды. Вызывать опухолевые изменения клеток лимфоидной ткани также могут такие методы лечения онкологических заболеваний, как лучевая терапия и прием цитостатических препаратов.
Классификация
Согласно гистологической классификации, выделяют более 30 разных видов опухоли. Большинство из них имеет В-клеточное происхождение. На долю Т-клеточных приходится лишь 15 % от числа всех лимфосарком.
Из клеток-предшественников может образоваться В-лимфобластный лейкоз. Также к опухолям, которые происходят из В-лимфоцитов, относятся:
- Диффузная В-крупноклеточная лимфома. Такое гистологическое строение встречается чаще всего.
- Фолликулярная лимфома.
- Мелкоклеточная лимфоцитарная лимфома и хронический лимфоцитарный лейкоз.
- Лимфома из клеток мантийной зоны.
- Лимфома из клеток маргинальной зоны.
Встречаются также и другие виды В-клеточных лимфосарком, например, волосатоклеточный лейкоз и лимфома Беркитта. Эти формы заболевания возникают редко.
К основным формам Т-клеточных новообразований относится Т-лимфобластная лимфома (лейкоз из клеток-предшественников) и зрелые, или периферические, опухоли. Зрелые лимфосаркомы данного типа включают в себя тонкокишечную, гепатоспленическую, панникулитоподобную и некоторые другие виды заболевания.
Стадирование опухоли осуществляется по следующим критериям:
- I стадии соответствует локализованное поражение одного из органов или одной лимфатической зоны.
- II стадия характеризуется вовлечением в онкологический процесс двух и более лимфатических областей или органа с наличием регионарных метастазов по одну сторону от диафрагмы.
- На III стадии наблюдается поражение лимфоузлов, органов, тканей по обе стороны диафрагмы.
- IV стадия проявляется общей диссеминацией процесса или изолированной опухолью в одном из органов с наличием отдаленных метастазов.
В зависимости от течения лимфосаркомы делят на индолентные (с благоприятным прогнозом), агрессивные и высокоагрессивные. Пациенты с индолентными формами болезни при отсутствии лечения живут около 7 — 10 лет, а с агрессивными — от нескольких месяцев до 1-2 лет.
![]()
Симптомы лимфосаркомы
Заболевание всегда начинается с образования одиночной опухоли, которая активно метастазирует лимфо- и гематогенным путем. Такой очаг может располагаться в лимфатическом узле (такое поражение называют нодальным) либо в другом органе или ткани (экстранодально). Симптоматика лимфосарком обусловлена расположением первичной опухоли:
- Поражение лимфоузлов шеи и средостения может вызвать сдавление пищевода и трахеи, что проявляется дискомфортом при глотании и кашлем.
- При локализации в грудной клетке (в частности, в лимфоузлах задней части средостения) лимфосаркома может давить на крупные сосуды. При этом появляются такие симптомы, как цианоз, отечность верхней половины тела и лица, нарушение дыхания, тахикардия.
- В брюшной полости и забрюшинном пространстве увеличенные лимфатические узлы при достижении значительного размера или расположении в функционально значимых зонах могут привести к кишечной непроходимости, желтухе, нарушению оттока лимфы из нижней половины тела (появляются отеки ног, половых органов, асцит).
- Неходжкинские лимфомы желудочно-кишечного тракта — один из наиболее распространенных экстранодальных вариантов. Симптомы заболевания обусловлены расположением лимфосаркомы и сходны с клиническими проявлениями других опухолей данной локализации.
- Лимфосаркома носоглотки склонна к быстрому росту и поражению рядом расположенных структур — верхнечелюстной пазухи, решетчатого лабиринта, глазницы. Поэтому среди симптомов данной формы опухоли может отмечаться снижение слуха, затруднение носового дыхания, экзофтальм.
- Поражение кожи проявляется по-разному. Опухоль может иметь вид медленно растущего одиночного узла, вокруг которого с течением времени образуется множество вторичных очагов. Высыпания, как правило, плотные и безболезненные, могут сливаться в единое образование с бугристой поверхностью. В редких случаях лимфосаркомы кожи протекают по типу того или иного дерматита.
Также первичные опухоли могут располагаться в костной ткани, ЦНС, яичке, молочной железе. Все эти формы заболевания отличаются злокачественным течением.
Осложнения
Помимо того, что крупные опухоли могут вызывать симптомы сдавления внутренних органов, течение заболевания может сопровождаться и другими осложнениями. При прорастании стенок желудка лимфосаркома может послужить причиной развития кровотечения. Также при неходжкинских лимфомах наблюдается иммуносупрессия, которая проявляется повышением восприимчивости к инфекциям, в том числе смертельно опасным. При опухолевом поражении костей повышается риск переломов.
Течение заболевания во время беременности
Лимфосаркома может сочетаться с беременностью. Возможны следующие варианты:
- Зачатие наступило в состоянии ремиссии.
- Опухоль была выявлена во время внутриутробного развития плода.
- Развился рецидив новообразования в период беременности.
Беременность и роды в период стойкой ремиссии не отягощают прогноза опухоли. Однако риск рецидивирования лимфосаркомы гораздо выше для тех пациенток, у которых зачатие происходит в течение первых 2-3 лет после полной стабилизации состояния. В связи с этим женщины должны быть предупреждены о необходимости применения контрацептивов в течение этого периода.
Лимфосаркома высокого риска, которая была диагностирована в первом триместре, служит показанием к прерыванию беременности. При обнаружении опухоли во втором и третьем триместре тактика ведения подбирается индивидуально, с привлечением таких специалистов, как онколог, неонатолог, терапевт, генетик. Учитывается степень распространенности заболевания и характер ответа на лечение.
При рецидиве опухоли прогноз для беременности самый неблагоприятный. В данной ситуации требуется применение высокотоксичных препаратов, прием которых несовместим с беременностью.
Диагностика
В связи с тем, что лимфосаркома может располагаться во всех органах и тканях, план обследования пациента должен включать в себя:
- Физикальный осмотр с исследованием всех групп периферических лимфоузлов.
- Рентген органов грудной клетки.
- УЗИ органов брюшной полости, в том числе печени, селезенки, внутри- и забрюшинных лимфатических узлов.
- Фиброларингоскопию, которая проводится с целью оценки поражения лимфоидной ткани глотки (кольцо Вальдейера).
- Гастроскопию с биопсией подозрительных участков слизистой.
- Стернальную пункцию и трепанобиопсию подвздошной кости (исключение — поражение костного мозга).
Также необходимо исследовать те органы, со стороны которых пациент испытывает дискомфорт. Некоторые особые клинические варианты лимфосаркомы требуют проведения дополнительных методов обследования. Например, при поражении оболочек головного и спинного мозга выполняют люмбальную пункцию с последующим цитологическим исследованием ликвора, а при расположении очага в ЦНС — КТ или МРТ на уровне локализации опухоли.
![]()
Специфических диагностических лабораторных тестов для лимфосарком нет. Повышение в крови уровня ЛДГ при формировании образований и прогрессировании процесса отражает активность заболевания и используется для прогнозирования.
Окончательный диагноз устанавливают на основании гистологического анализа биоптата опухоли с иммунофенотипированием. Целью этого исследования является определение В- или Т-клеточного происхождения очага и уровня нарушения клеточной дифференцировки. Допускается и цитологическая верификация, но только в тех случаях, когда процесс забора материала для гистологии сопряжен с определенными рисками.
Методы лечения
Определение тактики ведения больного производится с учетом локализации опухоли, ее морфологического типа, распространенности, а также общего состояния здоровья пациента. Основными методами лечения лимфосарком являются:
- Химиотерапия. Обычно используются различные сочетания препаратов (полихимиотерапия). Данный метод может применяться самостоятельно или в сочетании с лучевым лечением. Для опухолей с медленным прогрессированием и благоприятным прогнозом успешно применяется комбинированная терапия в виде «сэндвича»: 2-3 цикла полихимиотерапии, затем лучевая терапия, потом снова 2-3 цикла химиопрепаратов.
- Хирургическое лечение, которое используется в случае изолированного поражения какого-либо органа, в первую очередь, желудочно-кишечного тракта. При множественном метастатическом поражении, когда развивается угроза кровотечения, непроходимость кишечника и другие осложнения, могут проводиться циторедуктивные оперативные вмешательства — удаление части опухолевой массы с целью устранения основных симптомов.
- Лучевая терапия. Может применяться в качестве самостоятельного метода при лечении локализованных форм лимфосаркомы с низкой злокачественностью. Также данный вид лечения может быть использован в качестве паллиативной терапии.
![]()
Иногда при неэффективности терапии или рецидиве заболевания больному может потребоваться аутологичная трансплантация стволовых клеток периферической крови. Инновационным направлением в лечении лимфосаркомы является иммунотерапия, действие которой направлено на усиление естественной способности иммунной системы бороться с опухолью.
Прогноз и профилактика
Прогноз зависит от гистологического строения опухоли и стадии процесса. Местнораспространенные формы протекают относительно благоприятно: долгосрочная выживаемость около 50-60%. При генерализации процесса данный показатель снижается до 10-15%.
Негативно на прогноз всех пациентов, страдающих лимфосаркомой, влияют такие неблагоприятные факторы, как:
- Пожилой возраст.
- Увеличенный уровень ЛДГ.
- Наличие сопутствующих заболеваний.
- III-IV стадии онкологического процесса.
- Два и более экстранодальных очага.
Учитывая характер причин развития лимфосаркомы, профилактические мероприятия сводятся к предупреждению заражения перечисленными инфекциями, исключению контакта с токсическими веществами. Люди, которые по тем или иным причинам имеют риск развития данного заболевания, должны регулярно проходить обследование с целью своевременной диагностики и лечения опухоли.
Лимфосаркома - это злокачественная опухоль, морфологическим субстратом которой являются клеточные элементы лим-фоидного ряда, клинически характеризующаяся поражением лимфатических узлов и различных органов, лимфогенным и гематогенным метастазированием с лейкемизацией у 20% больных. В структуре заболеваемости злокачественными гемобластозами на долю лимфосарком приходится около 15%, по частоте они уступают лишь лимфогранулематозу. В большинстве случаев лимфосаркома имеет В-клеточное происхождение, Т-клеточные варианты встречаются гораздо реже.
Что провоцирует / Причины Лимфосаркомы:
Патогенез (что происходит?) во время Лимфосаркомы:
По типу роста выделяют нодулярные и диффузные лимфосаркомы. Для нодулярных лимфосарком характерен очаговый фолликулоподобный рост опухолевых клеток. При диффузных лимфосарком, которые отличаются более злокачественным течением, опухолевые клетки растут в виде пласта, не образуя каких-либо структур. Нодулярные лимфосаркомы нередко трансформируются в диффузные. В зависимости от характера опухолевых клеток диффузные лимфосаркомы разделяют на небластные (лимфоцитарные, пролимфоцитарные, лимфоплазмоцитарные) и бластные (лимфобластные, иммунобластные). Среди бластных форм выделяют лимфому Беркитта, или африканскую лимфому, распространенную преимущественно в Африке; ее происхождение связывают с вирусом Эпстайна - Барр. Для небластных форм лимфосарком характерно относительно более доброкачественное и длительное течение. Бластные формы отличаются крайне злокачественным течением, быстрой генерализацией процесса.
Симптомы Лимфосаркомы:
Лимфосаркома возникает в лимфатических тканях и по своему течению, скорости роста и прогнозу ближе к острым лейкозам, чем к лимфогранулематозу. Каких-либо излюбленных возрастных пиков при лимфосаркоме нет. Мальчики заболевают несколько чаще, чем девочки. Первые проявления заболевания зависят от первичного расположения опухоли.
Условно выделяются четыре наиболее частые локализации процесса:
- Лимфосаркома брюшной полости;
- Лимфосаркома лимфатических узлов грудной полости (средостения);
- Лимфосаркома носоглотки;
- Лимфосаркома периферических (шейных, подмышечных, паховых) лимфатических узлов.
Реже встречается изолированное поражение лимфосаркомой костей, мягких тканей, кожи, внутренних органов. В принципе лимфатическая ткань имеется во всем организме человека, поэтому возможно развитие лимфосаркомы в любом органе или ткани.
При возникновении опухоли в брюшной полости возможны два варианта клинической картины:
- при поражении кишечника рост опухоли приводит к его непроходимости, и ребенок поступает в стационар по срочным показаниям;
- при расположении опухоли вне кишечника ее рост ведет к увеличению живота в объеме, и дети поступают на лечение лишь в далеко зашедших стадиях процесса.
При тщательном расспросе родителей выясняется, что опухоль все же не развивалась бессимптомно. Родители указывают на малозаметные в начале заболевания признаки: у некоторых детей отмечались какие-то неясные боли в животе, изменения аппетита, поносы, чередующиеся с запорами. Так как эти явления были выражены не очень сильно, родители, а нередко и медицинские работники считали, что все это связано с погрешностями в диете, с наличием глистов и т. д.
При первичном поражении лимфосаркомой лимфатических тканей грудной клетки первыми проявлениями заболевания чаще всего бывают признаки, характерные для вирусных и воспалительных заболеваний: подъем температуры тела, кашель, недомогание. Одышка, отечность лица, расширение подкожных вен кожи грудной стенки, как правило, выявляются при далеко зашедшем опухолевом процессе. Лимфосаркома средостения отличается очень агрессивным течением, и бурно развивающаяся клиническая картина требует срочного специального лечения.
Диагностика Лимфосаркомы:
Наиболее информативным методом диагностики в поликлинических условиях является рентгенография грудной клетки, которая не очень охотно назначается в связи с преувеличенной опасностью вреда облучения.
Как ни странно, но лимфосаркома желез глоточного кольца диагностируется достаточно поздно, потому что имеющиеся патологические изменения мягкого неба, миндалин трактуются как проявление воспалительного процесса. Появление метастазов в шейных лимфатических узлах, что выражается их увеличением, заставляет более тщательно обследовать ребенка у ЛОР-специалиста. Из клинических признаков, на которые следует обращать внимание родителям, необходимо указать на изменения голоса, гнусавость, выделения из носа без явных признаков вирусных заболеваний типа ОРВИ или гриппа.
Лимфосаркома периферических лимфатических узлов (чаще первично поражаются шейные узлы) по своим клиническим проявлениям практически не отличается от той, которую мы описали ранее в разделе о лимфогранулематозе. Конечно, специалист, обследуя ребенка, уже при пальпации заметит разницу между этими заболеваниями, но излагать эти врачебные тонкости здесь особого смысла нет. По клиническому течению лимфосаркома, безусловно, отличается более бурным течением, чем лимфогранулематоз, и долечебный период определяется неделями, а не месяцами. При наличии лимфосаркомы очень вредно на течении заболевания сказывается применение тепловых процедур (особенно физиотерапии), под влиянием которых рост опухоли ускоряется. В связи с этим обстоятельством хотелось бы предостеречь от назначения любых методов лечения увеличенных лимфоузлов, если диагноз точно не установлен.
Лечение Лимфосаркомы:
Общеизвестно лечение лимфосаркомы химиотерапией, иногда облучением, и с генерализацией процесса - преимущественно полихимиотерапией. Хирургический метод лечения лимфосарком не применяется из-за быстрого прогрессирования болезни после операции и возникновения имплантационого процесса в ране. Лимфосаркома (лимфоцитарная, пролимфоцитарная, лимфобластная и иммунобластная) лечится преимущественно химиотерапией, и прогноз для жизни при всех вариантах заболевания остается сомнительным.
Особую трудность в лечении представляет генерализация процесса любой формы лимфосаркомы. Больные, как правило, в таком случае переводятся на симптоматическое лечение и продолжительность жизни их исчисляется неделями или несколькими месяцами.
Химиотерапия как преимущественный метод лечения лимфосарком дает в начале лечения быстрый положительный эффект. С каждым последующим курсом эффект лечения снижается. При генерализации процесса эффект лечения кратковременный и малоэффективный.
Профилактика Лимфосаркомы:
К каким докторам следует обращаться если у Вас Лимфосаркома:
Вас что-то беспокоит? Вы хотите узнать более детальную информацию о Лимфосаркомы, ее причинах, симптомах, методах лечения и профилактики, ходе течения болезни и соблюдении диеты после нее? Или же Вам необходим осмотр? Вы можете записаться на прием к доктору .
Лабораторная диагностика лимфосаркомы - анализы
Клиника лимфосаркомы - признаки
Клиническая картина лифосаркомы характерна для болезней клеточной системы иммунитета, благодаря местным и общим проявлениям, которые являются общими и с другими злокачественными пролиферациями.
Существуют объективные признаки моно-, олиго- или мультирегиональной локазализации, в зависимости от стадии I-IV, как и при болезни Ходжкина. Можно наблюдать гиперплазию периферических, медиастинальных ганглиозных групп, а также и гепатоспленические локализации и туморальные локализации в заднебрюшинных, латерально-аортических и мезентериальных ганглиях, детерминирующих образование доступных для пальпации масс.
Таким образом, гипертрофия, диагностицированная путем клинического обследования, сопровождается, в зависимости от локализации, симптомами компрессии в средостении или в определенных абдоминальных областях: синдром компрессии гепатического или спленического гилюса, синдром компрессии нижней полой вены.
Внутричерепные локализации или локализации на позвоночнике лимфосаркомы дают симптомы нервной компрессии, с неврологическими синдромами, характерными для зажимаемой нервной территории. Следует отметить симптомы кожной локализации с опухолями и инфильтрационными плакардами, иногда изъязвленными, которые можно диагностицировать лишь вследствие гистологического исследования с тем, чтобы установить отличие от болезни Сезари (Sezary), фунгусоидного микоза, а иногда и от болезни Годжкина.
Экстраганглиозные локализации во внутренних органах лимфосаркомы распознаются с трудом, так как они симулируют различные заболевания затронутых органов. Такими являются легочные или плевролегочные локализации, гепатические локализации или локализации в ппщевом тракте — желудке, тонкой кишке, реже в толстой кишке и, в порядке исключеия, в пищеводе (Kim и Dorfman). В таблице (по Kim и Dorfman) приводятся локализации по различным ганглиозным группам и во внутренних органах, в зависимости от гистологически преобладающего типа.
Вообще, при висцеральных формах диффузного типа и при недифференцированных или смешанных гистологических формах, отличие от ретикулярной саркомы устанавливается с трудом.
![Локализация лимфосаркомы]()
В Клинике Гематологии больницы Фундень, за последние 5 лет, в сотрудничестве с клиниками Хирургии и энтерологии, используя в текущей практике эндоскопические исследования, мы диагностицировали 35 случаев диггестивных лимфом, большей частью типа лимфоцитарных лимфом и в основном с хорошим ответом на лечение.
План исследований в виду стадиализации, тот же что и для болезни Ходжкина. Статистики показывают разную частоту локализаций для каждой ганглиозной группы и на определенных внутренних органах, в зависимости от различных форм диффузной лимфосаркомы или узловой лимфосаркомы. В основном медиастиналь-ная локализация бывает реже, чем при болезни Ходжкина, как и костная локализация. Однако локализация в диггестивном тракте, как и кожные локализации встречаются гораздо чаще.
Зато, намного реже бывают локализации в центральной нервной системе, за исключением типа низкодифференцированной диффузной лимфосаркомы у молодых лиц, у которых большую частоту имеют медиастинальные локализации и локализации в центральной нервной системе.
Общие признаки лимфосаркомы появляются в основном на более развитых стадиях, III и IV, которые принимают аспекты стадий III и IV Б, как и при болезни Ходжкина, с специальными симптомами паранеопластического типа. Типы Б с общими признаками бывают реже на I и II стадиях, но это зависит и от гистологического клеточного типа, который, при формах среднедифференцированной диффузной лимфосаркомы или низкодифференцированной диффузной лимфосаркомы может альтерировать общее состояние, до того, как определяется их распространение в той или иной ганглиозной группе или внутреннем органе.
Висцеральные формы, вторичные другим или первичным локализациям, сопровождаются с самого начала функциональными расстройствами, некоторые из них имея характер общих симптомов. Так например, локализации в костном мозге могут давать тяжелые гемоцитопении, с лейкемической разгрузкой или без таковой; гепатические, плевролегочные и неврологические формы детерминируют общие симптомы, в зависимости от экстенсивности захвата этих органов.
![Стадии болезни Ходжкина]()
Общие симптомы появляются главным образом при экстенсивных формах на III и IV стадиях, в результате иммунологической альтерации и различных явлений паранеопластического типа. Таким образом, возникают симптомы автоиммунного заболевания, в основном аутоиммунная гемолитическая анемия с полными или неполными антителами (Berceanu и сотр.), чаще всего при диффузных формах с распространением на многие ганглиозные группы (Jones и сотр.); появляются признаки иммунного дефицита с гипогаммаглобулинемией, особенно при недифференцированных клеточных типах, создающих значительное предрасположение к многократным микробным инфекциям.
Медуллярные локализации, в особенности в сочетании с спленическими, детерминируют гемоцитопению с характерными синдромами геморрагической пурпуры, анемии и инфекционный синдром вследствие гранулопении.
Расстройства секреции гамма-системы, наряду с синдромами гипогаммаглобулинемии, могут приводить к дисгаммаглобулинемиям с различными иммунопатологическими явлениями, которые могут включаться в группу 7 типов дисгамаглобулинемий (Berceanu). Следует особо отметить формы с криоглобулинемиями (Smith и сотр., Schultz и сотр.), с явлениями сосудистых поражений благодаря преципитированным макроагрегатам капилляров — почечных, кожных, центральной нервной системы; могут появляться явления синдрома Рейно (Baynaud), дисглобулинемичеокие сосудистые пурпуры и экссудативные полисерозиты.
Обычно полагается, что лимфосаркома — лимфома, которая может эволюировать с симптомами болезни Вальденштрема (Waldenstrom) по поводу моноклинальной гипергаммаглобулинемии тина IgM. Таким образом, возникает синдром плазматической гипервязкости со всеми его характеристиками: гиперглобулинемическая энцефалоневропатия, нефротический синдром, общие геморрагические симптомы благодаря интерференции коагулирующих факторов (McKenzie).
При диффузных формах, иногда сопровождающихся лейкемическими разгрузками, могут появляться автоиммунные сывороточные факторы, такие как ревматоидный фактор и люпусный фактор, которые однако реже вызывают симптомы болезни (Lea, McKenzie). В редких случаях может появляться нефротический синдром различного патогенеза: мембранозный гломерулит благодаря макроагрегатам, в формах с гиперсекрецией IgM или благодаря иммунным комплексам (Sutherland и сотр.), синдром компрессии на почечную вену ганглиозной массой.
Важно то, что все эти нарушения, детерминированные иммунными альтерациями, могут затихать или совсем исчезать в тех случаях, которые отвечают на специфическое лечение. Следует подчеркнуть, что в редких формах с секрецией тяжелых цепей появляются, помимо признаков общего иммунного дефицита, некоторые особые нарушения, как например диггестивная недостаточность, как это недавно отмечалось при описании средиземной лимфомы с синдромом малабсорбции.
Редактор: Искандер Милевски. Дата обновления публикации: 18.3.2021
Лабораторные исследования являются обязательными и их следует проводить согласно определенной схеме с целью постановки диагноза в первую очередь гистологической формы, затем типа и интенсивности иммунных альтераций клеточной системы иммунитета; такое же важное значение имеют исследования по стадиализации, с целью оценки ганглиозной и экстраганглиозной экстенсивности поражений.
Любой клинический признак лимфоганглиозной пролиферации, который не оказывается вторичным явлением другой болезни, должен возбуждать подозрение на злокачественную пролиферацию, либо как лейкемическую пролиферацию, либо как лимфому.
Всестороннее исследование периферической крови показывает существование или несуществование лейкемической пролиферации, что подтверждается исследованием костного мозга. Обычно, при формах с ограниченными локализациями, без затронутости костного мозга, как это бывает на I и II стадиях, периферическая кровь может быть нормальной. В зависимости от общей эволюции и от детерминаций в костном мозге, может появляться синдром гемоцитопении с анемией, нейтропенией, тромбоцитопенией.
Если не существует лейкемической разгрузки, лимфосаркома вообще не имеет характерной картины крови, а гемоцитопения может иметь множество причин. Рано появляющаяся анемия, как и тромбогранулопения, иногда сопровождающаяся автоиммунными расстройствами, должна внимательно исследоваться с тем, чтобы определить, не возникла ли она на почве миелолейкоза. Биопсии костного мозга, иногда повторные, когда миэлограмма оказывается недостаточной, могут уточнить диагноз благодаря лимфоидным инфильтрациям с альтерацией медуллярной паренхимы или без таковой.
Синдром, описанный как медуллярный лимфоидный склероз и рассматриваемый как самостоятельная болезнь, может являться начальной формой лимфосаркомы с ограниченными медуллярными поражениями, но с синдромом гипоплазии и медуллярного склероза.
Ганглиозная биопсия является первостепенным исследованием, определяющим диагноз лимфосаркомы, гистологического типа Д или У, в одной из цитологических форм, которую следует уточнить. Ганглиозная или спленическая пункция, способная принести несколько добавочных данных в отношении мономорфного или полиморфного клеточного типа, в отдельных случаях, не должна ни в коем случае использоваться с диагностической целью. В нашем опыте встречались крупные ошибки диагноза, поставленного на основе ганглиозной пункции.
Для гистологического диагноза применяются общепринятые методы окраски, как гематоксилин-эозин, Van Gieson или импрегнации серебром. Для некоторых случаев с клеточным лимфоплазмоцитарным преобладанием рекомендуются и окрашивания Giemsa на срезе, а также и метил-пирониновой зеленью, с целью уточнения содержания РНК в ядрах и цитоплазме, как субстрат базофильности.
Процесс коллагенизации, с интенсивностью склероза и своим узелковым расположением, а также и состояние ретикулиновой сети, хотя и исследуются в обычном порядке, однако им не придается такого важного значения для диагноза и прогноза, как при болезни Годжкина. Тем не менее такие исследования могут быть полезными в некоторых случаях для распознавания определенных форм лимфосаркомы и ретикулосаркомы: при первой, ретикулиновая сеть может сокращаться до исчезновения, в то время как при последней, она присутствует и иногда даже сильно увеличена.
Исследование иммунологических расстройств должно начинаться с неспецифических тестов, как например СОЭ. Она повышена в формах с гипергаммаглобулинемией, но и благодаря гуморальным реактивным неспецифическим факторам, как например фибриноген и альфа-2-глобулин.
![Лимфосаркома]()
Является также обязательным качественное и количественное определение протеинограммы для гаммаглобулинемической системы. Любое изменение в системе гамма требует определения типа моноклонального или поликлонального роста путем качественного иммуноэлектрофореза, и если можно, и количественного. Это дает сведения о аномалийной гиперсекреции того или иного класса Ig, обычно IgM, с сокращением других классов, что является характерным процессом для миелолейкоза.
В редких случаях могут появляться гиперсекреции тяжелых цепей, как моноклональный компонент, который невозможно уловить при помощи простого электрофореза, или может существовать гипогаммаглобулинемия.Уже известна и описана в соответствующих статьях взаимосвязь между злокачественными лимфомами и синдромом макроглобулинемии Вальденштрёма (Waldenstrom). Клинические признаки автоиммунного заболевания уточняются путем исследования автоантител с характеристиками гемагглютининов или полноценных или неполноценных гемолизинов, или ревматоидного или люпусного факторов.
Доказано сочетание лимфосаркомы с синдромом Сжёгрена (Sjogren), так что следует проводить исследования для диагностицирования этого автоиммунного заболевания при любой форме лимфосаркомы, когда существуют признаки, указывающие на ее возможное существование: гиперплазия слюневых желез, признаки сокращения слюневой и слезной секреции (Berceanu). В нашем опыте существуют случаи синдрома Сжёгрена с характером ретикулярной пролиферации. вначале, который затем определился клинически и гистологически как лиффузная лимфосаркома или узловая лимфосаркома.
Почечные исследования проводятся на основании подозрения нефротического синдрома или почечной недостаточности, иногда по поводу повышения мочевой кислоты и реже по поводу инфильтрации почечной ткани саркоматозными клетками. Нефротический синдром возникает обычно при лимфопролиферациях с гипергаммаглобулинемией типа IgM. Мембранозный гломерулит, хотя и малохарактерный, является особой формой макроглобулинемической почки. Благодаря методам иммунофлюоресценции и электронной микроскопии удалось определить природу мембранозных отложений, которые состоят из IgM (Seligman).
Интрадермореакции на антигены, обычно создающие позднюю сенсибилизацию, бывают нормальными вначале, становясь затем отрицательными на стадиях III, IV Б. Также нормальными оказываются вначале и тесты по эксплорации лимфоцита Т, как например бластическая трансформация на РНА, но которая альтерируется впоследствии, когда наступает иммуноклеточный дефицит. При диффузных формах с быстрым распространением и лейкемической трансформацией, тесты на клеточный иммунитет могут оказываться дефицитными сначала (Gociu и сотр., Jones и Salmon).
Исследования с целью определения типа пролиферированных клеток (Jaffe и сотр.) на срезах или на клеточной взвеси, для выявления лимфоцитов В, имеют важное значение и вошли в практику эксплорации для выработки диагноза или прогноза, который имеет другой характер при лимфомах типа Т.
В случае некоторых медиастинальных локализаций, когда существует подозрение на пролиферацию типа Т, рекомендуются специфические для этой клетки исследования: тест розеток с овечьими гематиями, тест бластической трансформации на РНА, а также и тесты на дифференциацию лимфоцитов В (Papamichali и сотр., Rabelino и сотр.).
Кроме этого, с целью дифференциации между гигантофолликулярной реактивной лимфомой и узловой лимфосаркомой, Rappaport и сотр. применили методы на маркеры лимфоцитов В, которые повидимому присутствуют при ретикулярной пролиферации и сокращаются или исчезают при миелолейкозе..
![Лимфосаркома кожи]()
Лимфомы типа Т были обособлены главным образом за последние 5 лет и их следует отличать посредством специфических маркеров поднаселения лимфоцитов Т, так как с клинической точки зрения, и с точки зрения ответа на лечение они отличаются от лимфом типа В. В основном, сильная спленомегалия в сочетании с медиастинальной аденопатией и кожными детерминациями, часто и совместно с лейкемической разгрузкой атипичных клеток, составляет характеристики лимфомы Т. Эволюция является всегда тяжелой, с устойчивостью к почти всем лечебным схемам (Katovsky и сотр.).
С помощью специфических моноклональных сывороток возможно уточнить природу лимфом Тh или Ts (Platsoucas). По более новой статистике Леннерта (Lennert), из 1977 случаев лимфом у 85,35% наблюдается тип В, в то время как лишь у 8,65% тип Т; 6% составляют клетки «null» без маркеров Т или В.
Исследования с целью стадиализации, преследующие как и при болезни Ходжкина, топографические детерминации на определенных ганглиозных группах — над- и субдиафрагмальных, спленических и висцеральных — должны проводиться в обязательном порядке, соблюдая тот же план, что и при болезнии Годжкина: клиническое обследование, торакально-медиастинальную рентгенографию, костную рентгеногрзфию, гепатоспленическую и иногда легочную сцинтиграмму. Недавно, костная сцинтиграфия с Тс начала давать результаты в ряде изотопных лабораторий со значительным опытом.
Лапаротомия со спленектомией, со взятием биоптического материала из лимфатического ганглия и печени, с остеомедуллярной биопсией из гребня подвздошной кости, считается в настоящее время, как и при болезни Ходжкина, оптимальным методом диагноза и стадиализации.
На значительном числе случаев, лапаротомия и спленектомия оказались единственными методами, благодаря которым можно было выяснить диагноз лимфосаркомы обычно узелковой, в трудных ситуациях с клинической и биологической точек зрения. Так например, при лимфопролиферативных на первый взгляд случаях, с гипергаммаглобулинемией, обычно с криоглобулинемией, иногда с признаками иммунного дефицита, спленические поражения уточнили диагноз лимфосаркомы, реже ретикулосаркомы
В случаях с медиастинально-легочными поражениями без затронутости периферических ганглиев и селезенки, гистопатологический диагноз выясняется с помощью биопсии после торакотомии или с помощью методов управляемой медиастиноскопии или бронхоскопии со взятием биоптического материала. В более редких случаях, с детерминациями в первичном диггестивном тракте, желудке или кишечнике, со специфическими для этих органов расстройствами, включая и рентгенографические изменения, диагноз уточняется только посредством гистологического исследования изъятого материала посредством хирургического вмешательства. За последние годы целый ряд случаев, в особенности желудочной лимфосаркомы, были диагностицитованы таким образом.
Положительный диагноз лимфосаркомы ставится на основе подтверждения лабораторными данными клинических данных. В первую очередь диагноз должен обязательно опираться на гистопатологическое исследование, иногда повторяемое на нескольких ганглиозных группах и при необходимости, подкрепленное спленектомией. Следует уточнить злокачественную природу опухоли — лимфосаркомы и гистологический тип — Д или У, с формами дифференциации пролиферированных лимфоцитов, определяя таким образом клеточные типы известных в настоящее время лимфосаркомы.
Гистопатологический диагноз лимфосаркомы надо дополнять, в виду разграничения общего клинического и биологического эффекта пролиферации, исследованиями крови и иммунными исследованиями: медуллярно-кровяной анализ, электрофорез и иммуноэлектрофрез, тесты на автоиммунное заболевание или на иммунный дефицит. Стадиализации является обязательной до терапевтического показания.
Читайте также: